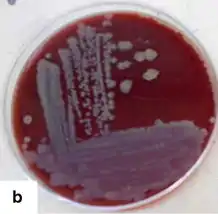

| Corynebacterium xerosis | |
|---|---|
![]() | |
| Gram stain of Corynebacterium xerosis | |
| Scientific classification | |
| Domain: | Bacteria |
| Phylum: | Actinomycetota |
| Class: | Actinomycetia |
| Order: | Mycobacteriales |
| Family: | Corynebacteriaceae |
| Genus: | Corynebacterium |
| Species: | C. xerosis |
| Binomial name | |
| Corynebacterium xerosis | |
Corynebacterium xerosis is a Gram-positive, rod-shaped bacterium in the genus Corynebacterium. Although it is frequently a harmless commensal organism living on the skin and mucus membranes, C. xerosis is also a clinically-relevant opportunistic pathogen that has been attributed to a number of different infections in animals and humans.[1][2] However, its actual prominence in human medicine is up for debate due to early difficulties distinguishing it from other Corynebacterium species in clinical isolates.
Characteristics
The genome of C. xerosis is approximately 2.7 million base pairs long with over 2,000 genes encoding proteins and a high G+C content.[1] C. xerosis was found to contain a series of plasmids, one of which confers resistance to common antibiotics such as chloramphenicol, kanamycin, streptomycin, and tetracycline and was named pTP10.[3] This plasmid has since been introduced into Bacillus subtilis and modified to generate a number of vectors for molecular cloning purposes.[4] In addition to having resistance to a number of antibiotics itself, at least one strain of C. xerosis also appears capable of producing its own antimicrobial compounds. These have the capacity to inhibit bacteria and fungi, but the strength of antimicrobial activity by this strain depended on the carbon sources available to it.[5] Also, a petroleum ether extract from C. xerosis was found to decrease the growth rate of tumors in mice, increasing their lifespan while being nontoxic to healthy mice.[6]
A study in 1967 confirmed the ability of several strains of C. xerosis to form single layer "clumps" of cells around gas bubbles when cultures of the bacteria are suspended in buffer solutions at low temperatures with vigorous stirring. This property was attributed to cell surface proteins.[7]
Clinical Relevance
Despite normally being a commensal organism, C. xerosis has been linked to many different opportunistic infections in humans and animals, including endocarditis, septicemia, abscesses, and osteomyelitis.[8][9][10][11][12] However, it is possible that many early reports of this bacterium may have been cases of misidentification: a 1996 study found that out of 25 clinical isolates originally identified as C. xerosis, all were actually Corynebacterium amycolatum based on a number of biochemical tests which came back as different from the C. xerosis reference strain.[13] Similarly, there is also evidence that some infections attributed to C. xerosis may have been caused by Corynebacterium striatum.[14] Therefore, it is difficult to determine the actual extent of C. xerosis infections as reported in historic literature; however, modern sequencing and phenotypic analyses have allowed for more accurate identification of C. xerosis in clinical infections.[15]
References
- 1 2 Wen, Fengqin; Xing, Xiaoyong; Bao, Shijun; Hu, Yonghao; Hao, Bao-cheng (2019-09-12). Putonti, Catherine (ed.). "Whole-Genome Sequence of Corynebacterium xerosis Strain GS1, Isolated from Yak in Gansu Province, China". Microbiology Resource Announcements. 8 (37). doi:10.1128/MRA.00556-19. ISSN 2576-098X. PMC 6742784. PMID 31515333.
- ↑ Palacios, Lucía; Vela, Ana Isabel; Molin, Kent; Fernández, Ana; Latre, Maria Victoria; Chacón, Gema; Falsen, Enevold; Fernández-Garayzábal, José Francisco (September 2010). "Characterization of some bacterial strains isolated from animal clinical materials and identified as Corynebacterium xerosis by molecular biological techniques". Journal of Clinical Microbiology. 48 (9): 3138–3145. doi:10.1128/JCM.02373-09. ISSN 1098-660X. PMC 2937682. PMID 20660219.
- ↑ Kono, Megumi; Sasatsu, Masanori; Aoki, Takashi (March 1983). "R Plasmids in Corynebacterium xerosis Strains". Antimicrobial Agents and Chemotherapy. 23 (3): 506–508. doi:10.1128/AAC.23.3.506. ISSN 0066-4804. PMC 184682. PMID 6847177.
- ↑ Kono, Megumi; Sasatsu, Masanori; Aoki, Takashi; Noguchi, Norihisa (March 1984). "Bacillus subtilisCloning Vectors Which Originated fromCorynebacterium xerosis". Agricultural and Biological Chemistry. 48 (3): 821–822. doi:10.1080/00021369.1984.10866225. ISSN 0002-1369.
- ↑ El-Banna, Nasser (2006). "Effect of carbon source on the antimicrobial activity of Corynebacterium kutscheri and Corynebacterium xerosis". African Journal of Biotechnology. 5: 833–835.
- ↑ Islam, Farhadul; Ghosh, Soby; Khanam, Jahan Ara (May 2014). "Antiproliferative and hepatoprotective activity of metabolites from Corynebacterium xerosis against Ehrlich Ascites Carcinoma cells". Asian Pacific Journal of Tropical Biomedicine. 4 (Suppl 1): S284–S292. doi:10.12980/APJTB.4.2014C1283. PMC 4025299. PMID 25183099.
- ↑ Stanley, S. O.; Rose, A. H. (1967-07-01). "On the Clumping of Corynebacterium xerosis as Affected by Temperature". Journal of General Microbiology. 48 (1): 9–23. doi:10.1099/00221287-48-1-9. ISSN 0022-1287.
- ↑ Bernard, K. (2012-07-25). "The Genus Corynebacterium and Other Medically Relevant Coryneform-Like Bacteria". Journal of Clinical Microbiology. 50 (10): 3152–3158. doi:10.1128/jcm.00796-12. ISSN 0095-1137. PMC 3457441. PMID 22837327.
- ↑ Vela, A. I.; Gracía, E.; Fernández, A.; Domínguez, L.; Fernández-Garayzábal, J. F. (June 2006). "Isolation of Corynebacterium xerosis from Animal Clinical Specimens". Journal of Clinical Microbiology. 44 (6): 2242–2243. doi:10.1128/JCM.02473-05. ISSN 0095-1137. PMC 1489389. PMID 16757629.
- ↑ Eliakim, R.; Silkoff, P.; Lugassy, G.; Michel, J. (October 1983). "Corynebacterium xerosis endocarditis". Archives of Internal Medicine. 143 (10): 1995. doi:10.1001/archinte.1983.00350100179034. ISSN 0003-9926. PMID 6625787.
- ↑ Hernández-León, Fernando; Acosta-Dibarrat, Jorge; Vázquez-Chagoyán, Juan Carlos; Rosas, Pomposo Fernandez; de Oca-Jiménez, Roberto Montes (December 2016). "Identification and molecular characterization of Corynebacterium xerosis isolated from a sheep cutaneous abscess: first case report in Mexico". BMC Research Notes. 9 (1): 358. doi:10.1186/s13104-016-2170-8. ISSN 1756-0500. PMC 4957927. PMID 27448802.
- ↑ Krish, G; Beaver, W; Sarubbi, F; Verghese, A (December 1989). "Corynebacterium xerosis as a cause of vertebral osteomyelitis". Journal of Clinical Microbiology. 27 (12): 2869–2870. doi:10.1128/jcm.27.12.2869-2870.1989. ISSN 0095-1137. PMC 267148. PMID 2592549.
- ↑ Funke, G; Lawson, P A; Bernard, K A; Collins, M D (May 1996). "Most Corynebacterium xerosis strains identified in the routine clinical laboratory correspond to Corynebacterium amycolatum". Journal of Clinical Microbiology. 34 (5): 1124–1128. doi:10.1128/jcm.34.5.1124-1128.1996. PMC 228967. PMID 8727888.
- ↑ Coyle, M B; Leonard, R B; Nowowiejski, D J; Malekniazi, A; Finn, D J (July 1993). "Evidence of multiple taxa within commercially available reference strains of Corynebacterium xerosis". Journal of Clinical Microbiology. 31 (7): 1788–1793. doi:10.1128/jcm.31.7.1788-1793.1993. ISSN 0095-1137. PMC 265633. PMID 8349754.
- ↑ Palacios, Lucía; Vela, Ana Isabel; Molin, Kent; Fernández, Ana; Latre, Maria Victoria; Chacón, Gema; Falsen, Enevold; Fernández-Garayzábal, José Francisco (September 2010). "Characterization of Some Bacterial Strains Isolated from Animal Clinical Materials and Identified as Corynebacterium xerosis by Molecular Biological Techniques". Journal of Clinical Microbiology. 48 (9): 3138–3145. doi:10.1128/JCM.02373-09. ISSN 0095-1137. PMC 2937682. PMID 20660219.
